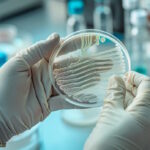
تفاوت میکروب و باکتری چیست؟ – به زبان ساده
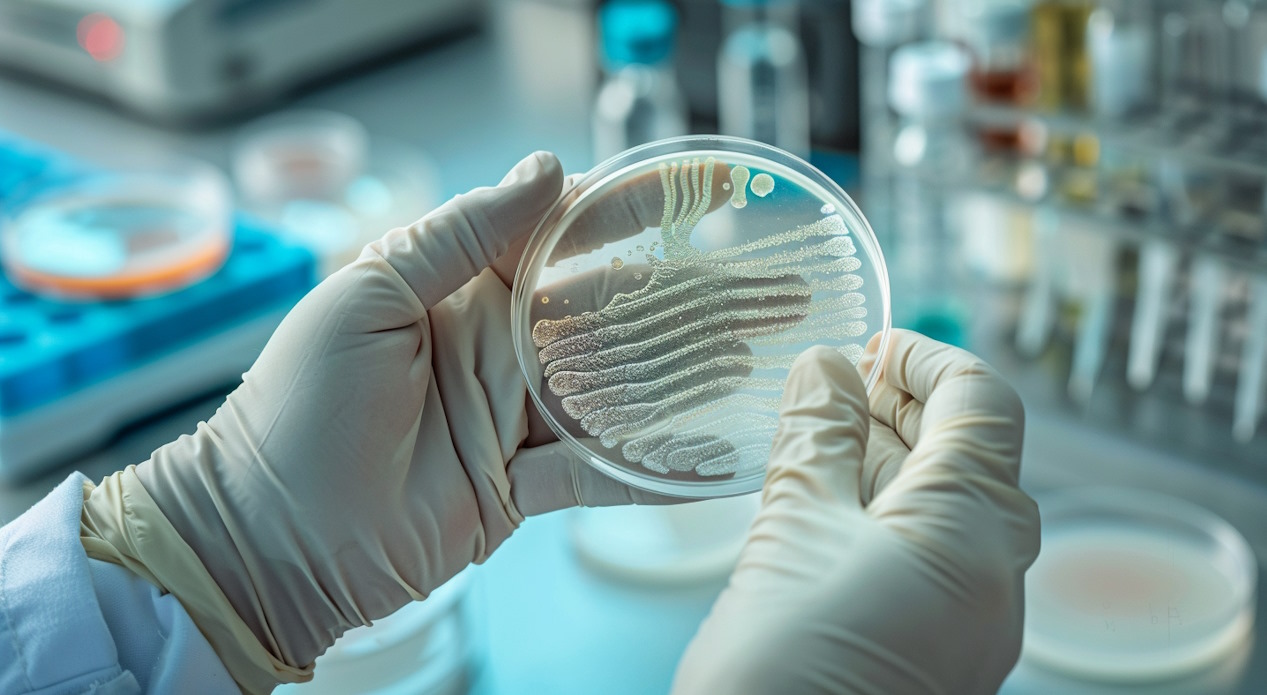
تفاوت میکروب و باکتری چیست؟ – به زبان ساده

تفاوت میکروب و باکتری چیست؟ – به زبان ساده
باکتریها میکروبهایی تکسلولی و فاقد هسته هستند. این موجودات میکروسکوپی تنها دسته میکروبها نیستند. قارچها، آرکیها، آغازیان و ویروسها در کنار باکتریها در دسته میکروبها قرار میگیرند. در این مطلب از مجله فرادرس با هدف قرار دادن تفاوت میکروب و باکتری به سراغ شناخت انواع میکروبها و آشنایی با میکروبیولوژی رفتهایم تا دیدی کاملتر از انواع مختلف میکروبها به دست بیاوریم.
- تفاوت اساسی میکروب، باکتری و میکروارگانیسم را یاد میگیرید.
- دستهبندی رایج میکروبها و ساختار هر گروه را خواهید شناخت.
- ویژگیهای کلیدی باکتری، قارچ، ویروس و آرکی را میشناسید.
- نقش و اهمیت هر گروه میکروبی در سلامت انسان را میآموزید.
- کاربرد صحیح آنتیبیوتیک و واکسن را متوجه میشوید.
- دلیل طبقهبندی متفاوت ویروسها و پریونها را یاد میگیرید.

تفاوت میکروب و باکتری
میکروب و باکتری دو گونه جدا نیستند که بتوان آنها را با یکدیگر مقایسه کرد. باکتریها دستهای از میکروبها هستند. به بیان دیگر واژه «میکروب» به گروهی گسترده از انواع موجودات میکروسکوپی اشاره دارد که شامل موارد زیر است.
- باکتریها
- آرکیها
- قارچها
- آغازیان
- ویروسها
بنابراین تمام باکتریها میکروب هستند، اما تمام میکروبها باکتری نیستند. در مورد به حساب آوردن ویروسها به عنوان میکروب بین دانشمندان اختلاف نظرهایی وجود دارد که در ادامه این مطلب از مجله فرادرس آنها را بررسی خواهیم کرد.

میکروب چیست؟
میکروبها موجوداتی میکروسکوپی هستند و کوچکتر از آن هستند که بتوان آنها را با چشم غیرمسلح دید ولی در همهجا حضور دارند، اطلاق نام میکروب نیز به این موجودات به دلیل همین سایز میکروسکوپی آنها است. میکروبها را میتوان در آب، خاک و هوا پیدا کرد، حتی بدن انسان نیز خانه میلیونها میکروب است.
بعضی از این جانداران میتوانند در زیستگاههایی با دمای بسیار بالا یا دماهای بسیار سرد زندگی کنند. میکروبها را میتوان در مکانهایی با فشار بالا نیز پیدا کرد. تعداد اندکی از آنها مانند «داینوکوکوس رادیودورانس» (Deinococcus radiodurans) در محیطهایی با میزان اشعه بالا زندگی میکنند.
میکروبها میتوانند تکسلولی، چندسلولی یا فاقد ساختار سلولی (Acellular) باشند. قارچها و آغازیان ازجمله میکروارگانیسمهای یوکاریوت هستند که اندامکهای غشادار را در آنها میبینیم. باکتریها و آرکیها نیز مثالی از میکروارگانیسمهای پروکاریوت هستند.
میکروبشناسها در گذشته برای جداسازی و شناسایی میکروبها به کشت، رنگآمیزی و میکروسکوپ تکیه میکردند اما با این روشها تنها میتوان ۱ درصد از میکروارگانیسمهای حاضر در محیطهای معمول را جدا کرد و کشت داد. با ظهور بیوتکنولوژی (زیست فناوری)، میکروبیولوژیستها به روشهای زیستشناسی مولکولی مانند شناسایی بر اساس توالی DNA تکیه کردهاند.
بعضی میکروبها ما را بیمار میکنند در حالی که بعضی دیگر برای سلامت ما ضروری هستند. رایجترین میکروبها، باکتریها، ویروسها و قارچها هستند. میکروبهای دیگری نیز وجود دارند که به آن ها پروتوزوآ میگویند، این دسته از میکروبها مسئول بیماریهایی مانند توکسوپلاسموز و مالاریا هستند. در ادامه این مطلب از مجله فرادرس دستههای مختلف میکروبها معرفی میکنیم اما پیش از آن به سراغ این سوال میرویم که تفاوت میکروب و میکروارگانیسم چیست؟
تفاوت میکروب و میکروارگانیسم
واژه «میکروب» به ویروسها میکروارگانیسمهایی نظیر باکتریها و قارچها گفته میشود. ویروسها به عنوان موجود زنده شناخته نمیشوند، بنابراین میکروارگانیسمها زیرمجموعه میکروبها هستند. میکروبها به طور معمول تکسلولی و پروکاریوت، یعنی بدون هسته سلولی، هستند.
میکروارگانیسم به موجودات زندهای گفته میشود که با چشم غیرمسلح دیده نمیشوند. میکروارگانیسمها شامل باکتریها، قارچها، آرکیها و آغازیان هستند. ویروسها و پریونها به دلیل غیرزنده بودن جزو میکروارگانیسمها دستهبندی نمیشوند. میکروارگانیسمها میتوانند پروکاریوت یا یوکاریوت باشند.
انواع میکروب ها
همانطور که تا اینجای این مطلب از مجله فرادرس گفتیم، میکروبها دستهای بزرگ و گسترده از موجودات هستند. از اصلیترین انواع میکروبها میتوان به باکتریها، ویروسها، قارچها، آرکیها و پریونها اشاره کرد که در ادامه هر کدام را با جزئیات بیشتری معرفی میکنیم تا دیدی واضحتر داشته باشیم که تفاوت میکروب و باکتری چیست.
باکتری
باکتریها موجودات زنده تکسلولی هستند. بعضی از آنها برای زندگی به اکسیژن نیاز دارند ولی گروهی از باکتریها بیهوازی هستند و نیازی به اکسیژن ندارند. بعضی از آنها گرمادوست هستند و در مقابل، بعضی از انواع باکتریها محیطهای سرد را ترجیح میدهند. از جمله شناخته شدهترین باکتریها میتوان به «سالمونلا» و باکتری استافیلوکوک اشاره کرد.
اکثر باکتریها برای انسانها بیخطر هستند، حتی بسیاری از آنها در بدن ما زندگی میکنند و به سلامتی ما کمک میکنند. برای مثال باکتری اسید لاکتیک در روده به هضم غذا کمک میکند. بعضی از باکتریها به واسطه مبارزه با دیگر میکروبها به سیستم ایمنی کمک میکنند. برای تولید انواع خاصی از مواد غذایی مثل ماست و پنیر نیز به باکتریها نیاز داریم.

کمتر از ۱ درصد از باکتریها بیماریزا هستند، البته این تخمین تقریبی است، زیرا تعداد دقیق باکتریهای بیماریزا مشخص نیست. عفونتهای باکتریایی را میتوان با «آنتیبیوتیکها» درمان کرد. آنتیبیوتیکها داروهایی هستند که باکتریها را از بین میبرند و یا تکثیر آنها را متوقف میکنند.
انواع دیگر عفونتها مانند سرماخوردگی، اسهال یا التهاب لوزهها میتوانند عامل باکتریایی داشته باشند ولی به طور معمول توسط ویروسها ایجاد میشوند. آنتیبیوتیکها در مقابل ویروسها کارآیی ندارند، بنابراین شروع مصرف این دسته از داروها زمانی که هنوز مطمئن نیستید که بیماری عامل باکتریایی دارد، فکر خوبی نیست.
در این مطلب از مجله فرادرس تفاوت میکروب و باکتری را بررسی کردیم، اما اگر مایل هستید که اطلاعات بهتر و بیشتری راجع به «باکتری» و «انواع باکتریها» کسب کنید، پیشنهاد میکنیم مطالب مربوط به این موضوعات را مطالعه کنید.
ویروس
برخلاف باکتریها، ویروسها ساختار سلولی ندارند و به همین دلیل آنها را جزو موجودات زنده به حساب نمیآوریم. ویروس ها از یک یا تعداد بیشتری مولکول تشکیل شدهاند که با یک پوشش پروتئینی احاطه شده است. ماده ژنتیکی داخل این پوشش برای تکثیر ویروس ضروری است.
بسیاری از ویروسها باعث بیماری میشوند، بعضی کمتر خطرناک هستند و یک سرماخوردگی خفیف ایجاد میکنند، در حالی بعضی دیگر از ویروسها میتوانند دلیل بیماریهای جدی مانند ایدز باشند. از دیگر بیماریهای ویروسی میتوان به کووید-۱۹، آنفولانزا و هپاتیت اشاره کرد.
ویروسها به سلولهای سالم حمله میکنند و با آلوده کردن آنها شروع به تکثیر میکنند. نکته مهم راجع به این تهاجم انگلوار ویروسها این است که ویروسها بدون این سلولهای میزبان توانایی تکثیر ندارند.
آلودگی به هر ویروسی باعث بروز علائم نمیشود و در اکثر موارد بدن با موفقیت با آلودگی ویروسی مبارزه میکند. برای مثال ویروس تبخال ازجمله ویروسهایی است که بسیاری از افراد به طور مقطعی به آن مبتلا میشوند. این ویروس در سلولهای عصبی خاصی به صورت غیر فعال وجود دارند و زمانی که سیستم ایمنی فرد ضعیف میشود به صورت زخمهایی روی لب علائم حضورشان را نشان میدهند.
مبارزه با ویروسها به وسیله درمانهای دارویی کمی سخت است اما یک روش محافظتی کارآمد این است که سیستم ایمنی را برای پاسخ دادن به آلودگی ویروسی تعلیم داده باشیم، به این منظور «واکسیناسیون» یک روش مناسب برای مبارزه بهتر بدن با بیماری ویروسی است.

آرکی
آرکیها پروکاریوتهایی تکسلولی هستند، بنابراین هسته و اندامک سلولی غشادار ندارند. آرکیها با وجود شباهتهایی که با باکتریها دارند از نظر ژنتیکی و بیوشیمیایی با باکتریها تفاوت دارند. برای مثال، غشای سلولی باکتریها از فسفوگلیسرید تشکیل شده است که دارای پیوند استری هستند در حالی که غشا آرکیها از لیپیدهای اتری تشکیل شده است.
آرکیها جاندارانی اکستریموفیل (Extremophiles) هستند که اصطلاح فارسی آن «شدید دوست» است. دلیل این دستهبندی به محیط زندگی آرکیها بر میگردد. آرکیها را میتوان در محیطهایی با شرایط زندگی سخت، مانند چشمههای آب گرم پیدا کرد. البته آنها را در همه زیستگاهها میتوان یافت.
قارچ
قارچها میتوانند در محیطهای گوناگونی زندگی کنند، برای مثال این دسته از میکروبها نیز مانند باکتریها به طور طبیعی روی پوست یا درون بدن وجود دارند و حتی میتوانند بیماریزا باشند. شناخته شدهترین قارچها مخمرها، کپکها و قارچهای خوراکی هستند.
بیماریهایی که توسط قارچها ایجاد میشوند را «میکوزیس» (Mycoses) یا «عفونت قارچی» میگویند. ازجمله مثالهای رایج عفونت قارچی میتوان به «پای ورزشکاران» (Athlete’s Foot) و «عفونت قارچی ناخن» اشاره کرد. عفونت قارچی گاهی میتواند ریهها یا غشای مخاطی دهان یا اندامهای تناسلی را درگیر کند. این نوع از عفونتهای قارچی میتوانند زندگی بیمارانی که سیستم ایمنی ضعیفی دارند را در خطر مرگ قرار دهند.
بعضی از انواع قارچها میتوانند برای مبارزه با بیماریها به بدن کمک کنند. برای مثال نوعی کپک به طور طبیعی پنیسیلین تولید میکند که برای مبارزه با باکتریها سودمند است.
پریون
پریون یک پروتئین کژتابیده (Misfolded Protein) است. اما پروتئین کژتابیده به چه معناست؟
پروتئینها دارای ساختارهای فضایی هستند که برای فعالیتهای آنها ضروری است. کژتابی پروتئین زمانی اتفاق میافتد که در مسیر تاشدگی پروتئین (Protein Folding) اشتباهی رخ بدهد و یک ساختار سمی ساخته شود. این نوع پروتئینها میتوانند روی پروتئینهایی که ساختار فضایی درست دارند، اثر بگذارند و آنها را تبدیل به مولکولهایی سمی کنند.
پریونها باعث تاخوردگی غیرنرمال انواع دیگر همان نوع پروتئینی میشوند که خودشان از آن مشتق شدهاند. این اتفاق منجر به مرگ سلولی میشود.

پریونها مسئول دستهای از بیماریها هستند که با نام «انسفالوپاتی اسفنجیشکل» (Transmissible Spongiform Encephalopathies | TSEs) شناخته میشوند. این بیماریهای کشنده که منجر به زول عقل می شوند، میتوانند هم انسان و هم حیوانات را درگیر کنند. تمام بیماریهای شناخته شده در پستانداران که دلیل آنها پریونها هستند، بر ساختار مغز یا سایر بافتهای عصبی تأثیر میگذارند. این بیماریهای پیشرونده، هیچ درمان موثر شناخته شدهای ندارند و همیشه کشنده هستند.
یادگیری میکروبشناسی و ویروسشناسی با فرادرس
میکروارگانیسمها و ویروسها بخشهای مختلف زندگی ما را تحت تاثیر خود قرار دادهاند. گستردگی علم میکروبشناسی به حدی است که طرح پرسشهایی مانند تفاوت میکروب و باکتری طبیعی به نظر میرسد. نقش این موجودات میکروسکوپی در سلامت و حتی صنایع مختلف غیرقابل انکار است به همین دلیل دانشمندان و متخصصان حوزههای مختلف به طور مداوم با گروههای متنوعی از میکروبها سروکار دارند.
با بررسی تعدادی از شاخههای مختلف میکروبها تا اینجای این مطلب از مجله فرادرس فهمیدیم که علاوه بر بیماریهای مختلفی که میتوانند منشا ویروسی، باکتریایی، قارچی یا آغازی داشته باشند، میکروبها میتوانند در بخشهای مختلف زندگی ما مثل غذایی که میخوریم تاثیر مستقیم داشته باشند. در صورتی که تمایل به آشنایی دقیقتر و تخصصیتر با هر یک از مباحث مربوطه داشته باشید، میتوانید از فیلمهای آموزشی فرادرس استفاده کنید. تعدادی از این دورههای آموزشی را در ادامه به شما معرفی میکنیم.
- فیلم آموزش میکروبیولوژی پزشکی فرادرس
- فیلم آموزش جامع و با مفاهیم کلیدی میکروبیولوژی صنعتی فرادرس
- فیلم آموزش واکسیناسیون و مراحل طراحی واکسن پروتئینی در محیط Insilico فرادرس
- فیلم آموزش آشنایی با مسمومیت غذایی و راه های پیشگیری از آن فرادرس
- فیلم آموزش جامع و با مفاهیم کلیدی بیوتکنولوژی میکروبی فرادرس

اگر تمایل دارید اطلاعات خود را در زمینه میکروبشناسی و ویروسشناسی افزایش دهید، به شما پیشنهاد میکنیم به صفحه مجموعه فیلمهای آموزش میکروبشناسی و ویروسشناسی فرادرس مراجعه کنید.
میکروبیولوژی چیست؟
میکروبیولوژی علم مطالعه میکروبها و یکی از زیرشاخههای اصلی زیستشناسی است. در بررسی تفاوت میکروب و باکتری با میکروبها و انواعشان آشنا شدیم و گفتیم که میکروبها میتوانند تکسلولی، چندسلولی یا فاقد ساختار سلولی باشند، به دلیل همین تنوع شاخههای متنوعی از میکروبیولوژی وجود دارد که شامل مواردی هستند که در جدول زیر آمدهاند.
|
«ویروسشناسی» (virology) علم مطالعه ویروسها |
«باکتریشناسی» (bacteriology) علم مطالعه باکتریها |
|
«آغازیشناسی» (protistology) علم مطالعه آغازیان |
«قارچشناسی» (mycology) علم مطالعه قارچها |
|
«جلبکشناسی» (Phycology) علم مطالعه جلبکها |
«ایمنیشناسی» (immunology) علم مطالعه سیستم ایمنی |
|
«انگلشناسی» (parasitology) علم مطالعه انگلها |
«نماتدشناسی» (Nematology) علم مطالعه نماتدها |
|
«فیزیولوژی میکروبی» (Microbial physiology) مطالعه نحوه فعالیت بیوشیمیایی سلولهای میکروبی |
«سیتولوژی میکروبی» (Microbial cytology) مطالعه جزئیات میکروسکوپی میکروارگانیسمها |
|
«اکولوژی میکروبی» (Microbial ecology) مطالعه رابطه میان میکروارگانیسمها و محیط زندگیشان |
«بیماریزایی میکروبی» (Microbial pathogenesis) مطالعه میکروبهای بیماریزا |
|
«ژنتیک میکروبی» (Microbial genetics) مطالعه نحوه سازماندهی و تنظیم ژنها در میکروبها |
«میکروبیولوژی سلولی» (Cellular microbiology) نقطه اتصال میکروبیولوژی و زیست شناسی سلولی به یکدیگر |
|
«میکروبیولوژی تکاملی» (Evolutionary microbiology) مطالعه تکامل میکروارگانیسمها |
«میکروبیولوژی نسل» (Generation microbiology) مطالعه میکروارگانیسمهایی با خصوصیات مشابه والدینشان |
|
«میکروبیولوژی سامانهها» (Systems microbiology) شاخهای میانرشتهای بین زیستشناسی سامانه ای و میکروبیولوژی |
«میکروبیولوژی مولکولی» (Molecular microbiology) مطالعه اصول مولکولی فرآیندهای فیزیولوژیکی در میکروارگانیسمها |
جمعبندی
این مطلب از مجله فرادرس را با جواب دادن به این سوال شروع کردیم که تفاوت میکروب و باکتری چیست؟ و متوجه شدیم که باکتریها یکی از انواع میکروبها هستند. بنابراین به سراغ شناخت میکروبها و انواع مختلف آنها رفتیم که در ادامه نام برده شدهاند.
- باکتریها
- قارچها
- آرکیها
- ویروسها
با توجه به این که دانشمندان ویروسها و پریونها را موجود زنده نمیدانند به سراغ یک سوال دیگر نیز رفتیم. تفاوت میکروب با میکروارگانیسم چیست؟
در اکثر موارد این دو واژه را معادل یکدیگر میدانند اما در مواجه با ویروسها تفاوت این دو مشخص میشود. «میکروارگانیسم» به موجودات میکروسکوپی زنده اشاره دارد که شامل ویروسها، ویروئیدها و پریونها نمیشود در حالی که «میکروب» هم شامل میکروارگانیسمهاست و هم ویروسها که فاقد ساختار سلولی هستند.













